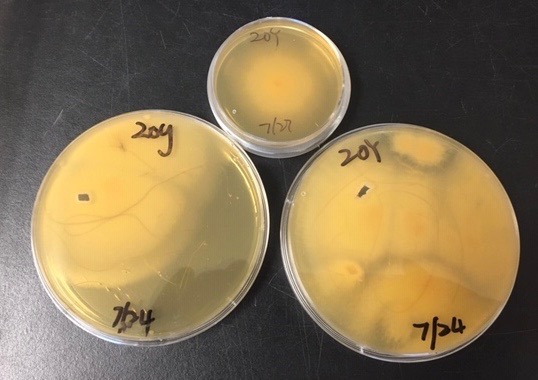
Pythium Pathogen grown from Chincoteage water samples

Archive for August, 2019
Some Schools Across Virginia Opened Before Labor Day, Effectively Ending “Kings Dominion Law”
Posted by Nick Gilmore in Virginia's News on August 30, 2019

Credit: Creative Commons / Flickr
Across Virginia, schoolchildren are heading back to school. And now school divisions are no longer required to wait until Labor Day to open their doors. Michael Pope reports.
Northam Inches Up in Polls
Posted by dseidelvtedu in Uncategorized on August 30, 2019

Gov. Ralph Northam
Polling from Roanoke College shows approval for Virginia Governor Ralph Northam is on the rise.
He’s up to a 37% approval rating. That’s a five point uptick since February when a racist photo was discovered on his medical school yearbook page.
Mallory Noe-Payne has this look at where Virginia’s Governor stands now, six months later.
Regulators: Dominion’s Profits $277 Million Too High
Posted by Nick Gilmore in Virginia's News on August 29, 2019
Virginia’s largest electric utility earned $277 million more in profits last year than what regulators say is reasonable and its customers could see huge bill increases in coming years, state regulators said Thursday in a new report. Mallory Noe-Payne has details.
Some Virginia Workers Are Continuing to Deal With Low Wages
Posted by Nick Gilmore in Virginia's News on August 29, 2019
Service sector employees in Virginia have been struggling for years with low wages. And now, they are looking ahead to an uncertain future. Michael Pope has the story.
Efforts to Limit Haze in National Parks May Be Hurt By New Federal Guidelines
Posted by dseidelvtedu in Uncategorized on August 28, 2019

Air pollution or haze hurts scenic views in Shenandoah National Park. The National Park Service has documented the effect on the park’s views back into the 1990’s.
(Credit” Interagency Monitoring of Protected Visual Environments)
When you think about a national park, you probably think about fresh air, but the fact is that pollution blows through many of our parks, including the Shenandoah.
The Environmental Protection Agency came up with a rule to address air quality, but park advocates complain that the Trump administration is getting in the way of improvements.
Sandy Hausman explains.
New Report: Virginia Economy Faces a Looming Slowdown
Posted by Nick Gilmore in Virginia's News on August 28, 2019
Is Virginia’s economy headed for a rough patch? Michael Pope looks into the crystal ball.
You can find the full report here.
Attorney General: Local Governments Can Exercise Zoning Authority Over Gun Stores
Posted by dseidelvtedu in Uncategorized on August 28, 2019

Credit: MBandman / Creative Commons
Do local governments across Virginia have zoning authority to tell gun stores where they can be located and, maybe more importantly, where they can’t be located?
Michael Pope reports.
Herring: Oklahoma Ruling Encouraging for Virginia Opioid Lawsuit
Posted by dseidelvtedu in Uncategorized on August 27, 2019

Creative Commons via flickr.com
A judge in Oklahoma ruled yesterday/Monday the company Johnson and Johnson is partially responsible for the opioid epidemic there. The drug-maker has been ordered to pay half a billion dollars.
Virginia wasn’t a party in that case, but as Mallory Noe-Payne reports the ruling could still have implications for the Commonwealth.
Roanoke College Poll: Democrats Have Momentum As Fall Campaign Approaches
Posted by dseidelvtedu in Uncategorized on August 27, 2019

Next week is Labor Day and the traditional beginning of the campaign season in Virginia.
As Michael Pope reports, a new poll shows Democrats are poised to do very well.
Virginia Marks Women’s Equality Day
Posted by dseidelvtedu in Uncategorized on August 26, 2019

US Census Bureau Data
Virginia marked Women’s Equality Day Monday.
But as Michael Pope reports, there’s still no equality between the genders in Virginia when it comes to pay.
Honoring Black Patriots
Posted by dseidelvtedu in Uncategorized on August 26, 2019

Charles Jameson looks on as fellow reenactors Charles Belfield, George Beckett and fire muskets in a salute to black patriots of the Revolutionary War.
(Credit: Pamela D’Angelo)
It’s been nearly two-and-a-half centuries since the Revolutionary War and still very little is known about Virginia’s black patriots.
Some were promised freedom and went into battle. Others produced weapons, clothing and food.
In the Tidewater Region, the Northern Neck of Virginia Historical Society is recognizing the role of black patriots in winning the war.
Pamela D’Angelo reports.
Virginia’s Tourism Industry Continues to Boom
Posted by Nick Gilmore in Virginia's News on August 23, 2019
Tourism is booming in Virginia. And, the forecast for the next decade is also strong. Michael Pope reports.
This Year’s Election Could Have Impacts on FMLA and Sick Leave in Virginia
Posted by Nick Gilmore in Virginia's News on August 23, 2019
When can employees take time off? And how much time should they get to leave work? Lawmakers are expected to consider these questions next year, and the results will depend on what happens during this year’s election. Michael Pope reports.
Protecting Student Borrowers
Posted by dseidelvtedu in Uncategorized on August 22, 2019

(Credit: 401(K) 2012 via Flickr.com / CC)
Is the federal government doing enough to protect people with student loans?
Michael Pope reports that one Virginia Congressman is seeking action on the issue.
The Appalachian Trail Hopes to Lure New Communities of Hikers
Posted by dseidelvtedu in Uncategorized on August 22, 2019

Shalin Desai celebrates completing his AT hike from Georgia to Maine. Now he’s organizing groups to enjoy and maintain the trail.
(Credit: Shalin Desai)
The Appalachian Trail stretches nearly 2,200 miles from Georgia to Maine, and it depends on volunteers to keep the path clear.
The Appalachian Trail Conservancy is now trying to interest more people in the job – especially those who have not, historically, been part of the hiking community.
Sandy Hausman has details.
‘Honoring the Journey’ 400 Years of African-American History at Fort Monroe
Posted by dseidelvtedu in Uncategorized on August 22, 2019

(Credit: Mallory Noe-Payne)
400 years ago, the first enslaved Africans arrived to English North America. That moment would set the trajectory of a nation.
The story begins in 1619. In western Africa, a village is raided and the people that lived there are put on a ship and forced to go to the New World. Through piracy and storms, about twenty land eventually in Point Comfort, Virginia.
Today the site is called Fort Monroe and it’s a National Monument.
Mallory Noe-Payne spoke about the history and future with Superintendent Terry Brown.
Seniors to Outnumber Children, Although Virginia Lags National Trend
Posted by Nick Gilmore in Virginia's News on August 21, 2019
The senior population in Virginia is about to experience a boom. Michael Pope explains why that’s important.
Public, Interest Groups Weigh In On Guns At Crime Commission
Posted by Nick Gilmore in Virginia's News on August 20, 2019

Credit: Mallory Noe-Payne / RADIO IQ
Virginia’s State Crime Commission heard hours of public testimony Tuesday – all on gun violence. As Mallory Noe-Payne reports, comments are falling along expected lines, but there is one emerging point of consensus.
Should Virginia Crack Down on Tax-Avoiding Corporations?
Posted by Nick Gilmore in Virginia's News on August 19, 2019
This week, Governor Ralph Northam will outline the state of Virginia’s finances to the House and Senate money committees of the General Assembly. And, opinions are divided about the best way to balance the books. Michael Pope reports.
In Richmond, Virtually all Juveniles Stopped for Curfew Violations Were African-Americans
Posted by dseidelvtedu in Uncategorized on August 19, 2019

Robert Morris, commissioner for RVA League for Safer Streets. Many of the young men he works with have been stopped by police. (Credit Mallory Noe-Payne)
Earlier this year Richmond Police released a trove of data. It revealed who in the city is stopped by law enforcement, and why.
The numbers show large racial disparities in stops for things like suspicious activity, and disorderly conduct.
Mallory Noe-Payne takes a look at the most drastic disparity– curfew violations.
Could A Public Option Health Plan Hurt Rural Hospitals in Virginia?
Posted by Nick Gilmore in Virginia's News on August 16, 2019

Credit: Wellness GM / Flickr
Democrats are divided about how much of America’s health insurance should be run by the government. That’s leaving some industry groups worried about the future of Virginia’s rural hospitals. Michael Pope reports.
Public Business Requires Advance Notice, Although it Doesn’t Always Work Out That Way
Posted by Nick Gilmore in Virginia's News on August 15, 2019
Members of the Norfolk School Board are facing criticism over meeting without public notice. It’s an issue that every Planning Commission and water-control board in Virginia has to deal with. Michael Pope reports.
Virginia Incumbents and Their Challengers Often Have More in Common Than Meets the Eye
Posted by Nick Gilmore in Virginia's News on August 14, 2019

Credit: NPR
Who are the people running against all those incumbent members of the Virginia General Assembly this year? And just how rich are they? Michael Pope reports.
Proposal for ICE Juvenile Center in Northern Virginia Meets Opposition
Posted by Nick Gilmore in Virginia's News on August 13, 2019
The Trump administration wants to build a new detention center for children in Northern Virginia. And, the idea isn’t all that popular in the region. Michael Pope reports.
A Peaceful Anniversary for Charlottesville
Posted by Nick Gilmore in Virginia's News on August 12, 2019

Charlottesville police kept a low profile as the city observed the second anniversary of Unite the Right. (Credit: RADIO IQ)
There were no protests, no chanting and no arrests this weekend as Charlottesville marked the second anniversary of a violent white supremacist rally. Instead, the city celebrated what it calls Unity Days – a range of events designed to bring people together. Sandy Hausman reports.
Two Years Later, Still No Conclusion Over What Caused Helicopter Crash
Posted by Nick Gilmore in Virginia's News on August 12, 2019

Credit: Virginia State Police via AP
Two years ago Heather Heyer was killed during the white supremacist rally in Charlottesville. Two others also died that day. Troopers Berke Bates and Jay Cullen were killed when their helicopter crashed. Mallory Noe-Payne reports.
With Republicans in Washington Considering Gun Control, Will the Virginia GOP Follow Suit?
Posted by Nick Gilmore in Virginia's News on August 12, 2019
Are Republicans in Virginia on the verge of moving their position on gun control? Michael Pope reports.
Appalachia to become Hotter Wetter AND Drier in Climate Model with Severe Economic Impacts
Posted by dseidelvtedu in Uncategorized on August 12, 2019

Appalachia is known for its abundance of water. But a new study finds that climate change could have a strange effect here, causing both more floods and more droughts.
Robbie Harris reports.
Virginia Transit Projects Show How Off Cost Estimates Can Sometimes Be
Posted by Nick Gilmore in Virginia's News on August 9, 2019
Estimating the cost of major transit projects can be difficult. And a new federal report points to Virginia as an example of how cost estimates can be dramatically wrong. Michael Pope reports.
Changing Climate May be Moving a Subtropical Disease North
Posted by dseidelvtedu in Uncategorized on August 9, 2019
Pythium Pathogen grown from Chincoteage water samples. (Credit Erica Goss)
At Chincoteague National Wildlife Refuge on the Eastern Shore, a herd of wild ponies is under attack by a deadly infection.
So far, eight female ponies have died, and the volunteer fire department that owns the herd is fighting to prevent additional deaths.
Pamela D’Angelo reports the region’s changing climate is creating an ideal environment for the disease.
Scientists Stalk a Microscopic Monster Killing Chincoteague’s Famous Ponies
Posted by dseidelvtedu in Uncategorized on August 9, 2019

Veterinarian Richard Hansen inspects ponies. (Credit Pamela D’Angelo)
For the past three years, a mysterious micro-organism has been infecting the famous wild ponies of Chincoteague National Wildlife Refuge.
The infection is known as swamp cancer and it has killed eight female ponies so far.
The volunteer fire department that owns the herd and the U.S. Fish and Wildlife Service, which oversees the refuge, have brought in scientists and veterinarians to try to eliminate the culprit and cure the disease.
Pamela D’Angelo reports.
Medicaid Enrollment Numbers Offer Hope for Maternal Mortality Rate
Posted by Nick Gilmore in Virginia's News on August 8, 2019
The crisis of maternal mortality among African-American women in Virginia continues to raise alarm bells among state officials, although a new report has some good news on the subject. Michael Pope reports.
Activists Want Twitter to Ban White Supremacists
Posted by Nick Gilmore in Virginia's News on August 8, 2019

Activists say white supremacists are using Twitter to promote hate. The company says it has policies against that. (Credit: Twitter)
Community activists from Charlottesville are asking Twitter to ban white supremacists in advance of August 12th – the 2nd anniversary of a violent rally called Unite the Right. RADIO IQ’s Sandy Hausman has that story.
Virginia Leaders on Both Sides of the Aisle Want to End the ACA’s “Cadillac Tax
Posted by Nick Gilmore in Virginia's News on August 7, 2019
Washington isn’t a place that’s known for bipartisan agreement on many things. But, as Michael Pope reports, Republicans and Democrats from Virginia are coming together in an effort to repeal a key part of the Affordable Care Act.
Elections Board Denies GOP Another Chance in Central Virginia District
Posted by Nick Gilmore in Virginia's News on August 6, 2019

Credit: BingBong321 / Creative Commons
Virginia’s Board of Elections will not allow Republican Delegate Nick Freitas on the ballot this November. That decision came during a board meeting Tuesday. Mallory Noe-Payne reports.
Northam Blasts Trump After Mass Shootings
Posted by Nick Gilmore in Virginia's News on August 5, 2019

Following an event marking the 75th birthday of Smokey Bear, Governor Northam blasted President Trump and state lawmakers who failed to act during a special legislative session on gun control. (Credit: RADIO IQ)
In the wake of two mass shootings over the weekend, Governor Northam is blaming Donald Trump and calling on voters to reject gun violence on November 5th. Sandy Hausman has the story.
Some Virginia Districts Are Turning to Virtual Solutions to Teacher Shortage
Posted by Nick Gilmore in Virginia's News on August 5, 2019

Credit: Marcie Casas / Creative Commons
Schools across Virginia are having a hard time finding teachers. And, the lack of teachers in Virginia is causing some schools to take drastic measures. Michael Pope reports.
Va. News: Highway tolls bringing in their Share of Money, private War Games in Hanover County
Posted by dseidelvtedu in Uncategorized on August 5, 2019
Private war games in Hanover County have some neighbors upset. And the toll road industry in the Hampton Roads area is now bigger than some of the region’s better known economic mainstays.
Those have been among the most read stories over the past week at the Virginia Public Access Project’s Va. News link.
More now from Fred Echols.
Northam Outlines School Readiness Proposal
Posted by Nick Gilmore in Virginia's News on August 2, 2019
Virginia Governor Ralph Northam is hoping to get his hands on new funding streams for early childhood education. Michael Pope reports.
‘We Will Win It’ Says GOP Delegate Who Missed Filing Deadline
Posted by Nick Gilmore in Virginia's News on August 1, 2019

Republican Delegate Nick Freitas (Credit: BingBong321 / Creative Commons)
A GOP state lawmaker says he’s willing to step aside as a candidate, if it means voters in his district can get a Republican on the ballot. The election in central Virginia could impact party control of the statehouse. Mallory Noe-Payne reports.
Measure Honoring Virginia Beach Shooting Victim Headed to the White House
Posted by Nick Gilmore in Virginia's News on August 1, 2019

Congresswoman Elaine Luria, who introduced the legislation honoring Ryan Keith Cox.
It’s been two months since the Virginia Beach mass shooting, and the scars are still healing. Michael Pope has this report about one of the heroes of that day.

